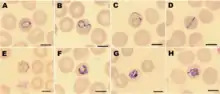

متصورة نولسية
المُتَصَوِّرَة النُّولِسِيَّة(1) (الاسم العلمي: Plasmodium knowlesi) هي طفيليٌ يُسبب الملاريا في البشر والرئيسيات. تُوجد في جميع أنحاء جنوب شرق آسيا، وهي المُسبب الأكثر شيوعًا لملاريا البشر في ماليزيا. دورة حياة النولسية كغيرها من أنواع المتصورة، تتطلب إحداث العدوى في بَعُوضةٍ ومضيفٍ من ذوات الدم الحار. قد يُصاب الإنسان بالعدوى عبر بعوضةٍ مصابةٍ بها، وذلك على الرغم من أنَّ سعادين العالم القديم تُعد المضيف الطبيعي للنولسية. تندرج المتصورة النولسية تحت حقيقيات النوى ضمن شعبة معقدات القمة وجنس المتصورة، كما ترتبط ارتباطًا وثيقًا بالمُتصوِّرة النَّشيطَة، وهي من الطفيليات البشرية، وغيرها من أنواع المتصورة التي تصيب الرئيسيات غير البشرية.[1]
اضغط هنا للاطلاع على كيفية قراءة التصنيف المتصورة النولسية | |
|---|---|
![]() مسحاتٌ مصبوغةٌ بصبغة جيمزا لمُتصورةٍ نُّولسيَّة أصابت خلايا دم حمراء بشرية | |
| المرتبة التصنيفية | نوع |
| التصنيف العلمي | |
| غير مصنف: | النواتح |
| المملكة: | الأسناخ الصبغيَّة |
| العويلم: | الطلائعيات السناخيَّة |
| الشعبة: | معقدات القمة |
| الطائفة: | اللامخروطانية |
| الرتبة: | البوغيات الدموية |
| الفصيلة: | المتصورات |
| الجنس: | المتصورة |
| النوع: | المتصورة النولسية |
| الاسم العلمي | |
| Plasmodium knowlesi سينتون وموليغان، 1932 | |
قد يَحدُث لدى البشر المُصابين بالمتصورة النولسية ملاريا غَيرُ مصحوبةٍ بمُضاعفات أو ملاريا شديدة مشابهةٌ لتلك التي تُسببها المُتصوِّرة المِنْجَليَّة. يُعد تشخيص النولسية أمرًا صعبًا؛ وذلك لأنها تُشبه بشكلٍ كبيرٍ الأنواع الأخرى التي تُصيب البشر. كما أنَّ علاجها مشابهٌ للأنواع الأخرى للملاريا، حيث عادةً ما يوصى باستعمال الكلوروكين أو العلاج المُركب بالأرتيميزينين. تعد ملاريا المتصورة النولسية مرضًا ناشئًا حيث كان يُعتقد سابقًا أنه نادر الحدوث لدى البشر، ولكنه يومًا بعد يوم أصبح يُشكل عبئًا صحيًا كبيرًا في جنوب شرق آسيا.[2]
وُصفت المتصورة النولسية لأول مرةٍ على أنها نوعٌ مستقلٌ ومُسببٌ محتملٌ للملاريا البشرية في عام 1932. استُخدمت لفترةٍ قصيرةٍ في أوائل القرن العشرين لإحداث الحمى كعلاجٍ للزُّهْري العصبي. أصبحت في منتصف القرن العشرين أداةً شائعةً لدراسة المتصورة في علم الأحياء، كما استُخدمت في الأبحاث الأساسية وأبحاث اللقاحات وتطوير الأدوية. لا تزال النولسية تستعمل نموذجًا مخبريًا للملاريا؛ وذلك لأنها تصيب بسهولةٍ المكاك الريسوسي، وهو النموذج الحي للرئيسيات، كما يُمكن أن تنمو في مزرعةٍ خلويةٍ من دم الإنسان أو المكاك.[3]
دورة الحياة

تمتلك المتصورة النولسية دورة حياةٍ كغيرها من طفيليات المتصورة، حيث تتطلب انتقالها ذهابًا وإيابًا بين مضيفاتٍ من الثدييات ومضيفاتٍ من الحشرات. تُصاب الرئيسيات بالعدوى عبر لسعةٍ من بعوضة أنوفيلة مصابةٍ والتي تحمل الطفيلي في المرحلة البَوغيَّة في غددها اللعابية. تتبع البَوغيَّات تدفق الدم إلى كبد الرئيسيات حيث تتطور وتتكاثر على مدى خمسة إلى ستة أيام قبل أن تنفجر، وتطلق الآلاف من الخلايا الوليدة التي تُسمى الأَقاسيم (جمع أُقْسومَة) في الدم (لا تستطيع المتصورة النولسية إنتاج هاجِعاتٍ كامنة في الكبد، وذلك على عكس المتصورة النشطية).[4][5] ترتبطُ الأَقاسيم الموجودة في الدم بخلايا الدم الحمراء لدى الرئيسيات وتغزوها. يَمُر الطفيلي داخل خلية الدم الحمراء بعددٍ من المراحل التي يتمايز خلالها شكليًا، وتسمى الدَّور الحلقي، والأُتروفة (يتراوح حجمها ما بين 1.5 إلى 6 ميكرومتر)، والمُتَقَسِّمة (يتراوح حجمها ما بين 5 إلى 6 ميكرومتر).[6] في نهاية المطاف، تنفجر خلايا الدم الحمراء المُصابة بالمُتقسمة، مطلقةً ما يصل إلى 16 أقسومةً جديدةً في مجرى الدم، والتي تُصيب خلايا دم حمراء جديدة وتستمر بنفس الدورة.[4][7] تُكمل المتصورة النولسية دورتها في خلية الدم الحمراء كل 24 ساعة، مما يجعلها سريعةً بشكلٍ فريد بين أنواع المتصورة التي تصيب الرئيسيات (والتي تستغرق عادةً 48 أو 72 ساعة).[5] تتطور الطفيليات التي تغزو خلايا الدم الحمراء أحيانًا على مدار 48 ساعة تقريبًا إلى أشكالٍ جنسيةٍ مُميزة تسمى الخلية المشيجية الصغيرة أو الكبيرة، وذلك بدلًا من إكمالها دورتها الجنسية الاعتيادية داخل خلايا الدم الحمراء.[4][7] تبقى هذه الخلايا المشيجية في الدم حتى تبتلعها بعوضة.[4][7]
تبتلع البعوضة الخلايا المشيجية عندما تحصل على وجبةٍ دموية من مضيفٍ رئيسيٍ مُصاب بها. بمجرد دخولها إلى أمعاء البعوضة، تتطور الخلايا المشيجية إلى جاميتاتٍ ثم تندمج لتكوين زيجوت ثنائي الصبغة.[4] ينضج الزيجوت إلى زيجوتٍ مُتحرِّك، والذي يُهاجر عبر جدار أمعاء البعوضة ويتطور إلى البيضة المُخصبة المُتكيِّسة.[4][8] ثم تُطلق البويضة آلافًا من البَوغيَّات التي تهاجر عبر البعوضة إلى الغدد اللعابية.[4] تستغرق هذه العملية كاملةً في البعوضة من 12 إلى 15 يومًا.[5]
علم الأحياء الخلوي
مقالة مفصلة: متصورة

تُشبه المتصورة النولسية الأنواع الأخرى للمتصورة بشكلٍ كبير في بيولوجيا الخلية. يتكون مجموعها الوراثي (الجينوم) من 23.5 ميغا قاعدة من الحمض النووي الريبوزي منقوص الأكسجين (DNA) مقسمةً على 14 كروموسومًا.[2] تحتوي تقريبًا على 5,200 جينًا مشفرًا للبروتينات، 80% منها تمتلك جيناتٍ متحدة الأصل في المتصورة المنجلية والنشيطة.[2] يحتوي مجموعها الوراثي على عائلتين كبيرتين من الجينات الفريدة للنولسية: عائلة مُتغير تَراصّ الخلايا المصابة بالمُتَقَسِّمة (SICAvar) والتي تلعب دورًا في إظهار مولدات الضد المختلفة على سطح الطفيلي لتفادي جهاز المناعة، وعائلة تكرار مُتخلَّل النولسية (Kir) والتي تلعب دورًا في التصاق خلايا الدم الحمراء المصابة بالطفيلي بجدران الأوعية الدموية.[2]
بصفتها من معقدات القمة، فإنَّ المتصورة النولسية تمتلك العديد من الهياكل المميزة في نهايتها القمية المُتخصصة في غزو خلايا المُضيف، وتتضمن الخيوط القوسية [الإنجليزية] البَصَلِيّة الكبيرة، والخيوط المكروية الأصغر، والحبيبات الكثيفة [الإنجليزية] المتفرقة، حيث يُفرز كل منها عوامل فاعلة للدخول إلى الخلية المضيفة وتعديلها.[9][10] أيضًا كغيرها من معقدات القمة، فهي تمتلك عضيتين خلويتين من أصلٍ تعايشي، وهي: صانعة قمة وميتوكندريون مُنفرد كبير، حيث يُشارك كليهما في أيض الطفيلي.[11]
التطور والتصنيف
تتشابه المتصورة النولسية شكليًا مع المُتصورة الوَبالِيَّة المَلاريَّة، إلا أنها ترتبط ارتباطًا وثيقًا بالمتصورة النشطية بالإضافة إلى الأنواع الأخرى للمتصورة والتي تُصيب الرئيسيات غير البشرية.[1] عاش آخرُ سَلفٍ مُشتركٍ لجميع سلالات المتصورة النولسية الحديثة منذ حوالي من 98,000 إلى 478,000 سنة.[1] من بين الطفيليات البشرية، فإنَّ المتصورة النولسية ترتبط ارتباطًا وثيقًا بالمتصورة النشيطة، والتي تشعبت منها منذ ما بين 18-34 مليون سنة.[2][3] يظهر بالأسفل شجرة تطور السلالات، حيث تُقارن بين أنواع المتصورات التي تصيب البشر:[2]
| جُنَيْس المتصورة |
| ||||||||||||||||||
تتنوع جَمْهَرَة طفيليات المتصورة النولسية جينيًا أكثر من المتصورة المنجلية أو النشيطة. تتضمن النولسية ثلاث جمهراتٍ فرعية متميزة جينيًا.[2] توجد اثنتين منهما في نفس مناطق بورنيو الماليزية وقد تصيبان بعوضًا مختلفًا.[2] عُثر على الثالث فقط في معزولاتٍ مخبريةٍ مصدرها أجزاء أخرى في جنوب شرق آسيا.[2] لا يمكن تمييز جمهرات النولسية المعزولة من قرود المكاك جينيًا عن تلك المعزولة من العدوى البشرية، مما يشير إلى أنَّ نفس الجمهرات قد تُصيب البشر والمكاك بالتبادل.[12]
وُصفت ثلاثة أنواعٍ فرعية من المتصورة النولسية اعتمادًا على الاختلافات في مظهرها في لطخاتٍ دموية مصبوغة: المتصورة النولسية الإديسونية (الاسم العلمي: P. knowlesi edesoni)، المتصورة النولسية السينتونية (الاسم العلمي: P. knowlesi sintoni)، المتصورة النولسية الأريماية (الاسم العلمي: P. knowlesi arimai)، والتي عُزلت من ماليزيا وجاوة وتايوان على الترتيب.[5][13] العلاقة بين هذه الأنواع الفرعية الموصوفة والجمهرات الموصوفة في المؤلفات الحديثة غير واضحةٍ.[5]
الانتشار
عُثر على المتصورة النولسية في جميع أنحاء جنوب شرق آسيا، حيث تصيب أساسًا المكاك طويل الذيل ومكاك ذيل الخنزير واللانغور السومطري أسود التاج بالإضافة إلى بعوضة الأنوفيلة الهاكرية (الاسم العلمي: Anopheles hackeri) في شبه جزيرة ماليزيا والأنوفيلة المستترة (الاسم العلمي: Anopheles latens) في سراوق.[4] قد تُصاب قرود المكاك طويل الذيل في البرية بالمتصورة النولسية دون ظهور مرضٍ واضحٍ عليها، وحتى عندما تُصاب في نفس الوقت بأنواعٍ مُختلفة من أنواع المتصورة.[5][3] نادرًا ما يُعثر على المتصورة النولسية خارج جنوب شرق آسيا، ويرجع ذلك على الأرجح إلى أنَّ البعوض الذي ينقله ينحصر في تلك المنطقة.[12]
إمراض البشر
قد تُسبب المتصورة النولسية ملاريا غَيرُ مصحوبةٍ بمُضاعفات أو ملاريا شديدة في البشر. يُعاني المصابون بالعدوى دائمًا من حمى وقشعريرة.[14] غالبًا ما يُعاني الأشخاص المُصابون بملاريا المتصورة النولسية غير المصحوبة بمُضاعفاتٍ، من أعراضٍ تشملُ الصداع وآلام المفاصل والتوعك وفُقدان الشهية.[14] وبشكلٍ أقل شيوعًا، كان بعض الأشخاص قد عانوا من سعالٍ وآلامٍ في البطن وإسهالٍ وغثيانٍ وقيء.[14] تُظهر الاختبارات المعملية للأشخاص المصابين دائمًا انخفاضًا في عدد الصفائح الدموية، وذلك على الرغم من أنَّ هذا الأمر نادرًا ما يؤدي إلى مشاكل نزفية.[14] تميل المتصورة النولسية إلى إحداث حمى ترتفع كل 24 ساعة، وذلك على عكس الملاريا البشرية الأخرى، لذلك يُطلق عليها أحيانًا الملاريا اليومية أو ملاريا الحمَّى اليَوميَّة.[14][15] يُمكن علاج ملاريا المتصورة النولسية غير المصحوبة بمضاعفاتٍ بمضادات الملاريا.[14]
تحدث الملاريا الشديدة فيما لا يقل عن 10% من المصابين بالمتصورة النولسية.[12] تُشبه الملاريا الشديدة التي تُسببها المتصورة النولسية الملاريا الشديدة التي تُسببها المتصورة المنجلية. قد يُعاني الأشخاص المُصابون بمرضٍ شديد من ضيقٍ في التنفس وآلامٍ في البطن وقيء.[14] مع تطور المرض، تتضاعف الطفيليات إلى مستوياتٍ عالية جدًا في الدم مما قد يُسبب إصابةً حادةً في الكلى ويرقان وصدمة وضيق في التنفس.[14][16] من غير الشائع حدوث الحماض الأيضي، ولكن قد يحدث في الحالات الشديدة خصوصًا.[16] على عكس الملاريا المنجلية، نادرًا ما تسبب الملاريا المتصورة النولسية الشديدة غيبوبة أو فقرًا شديدًا في الدم.[14][16] تكون حوالي 1-2% من الإصابة مميتةً.[12]
التشخيص

تُشّخص الملاريا عادةً عبر فحص اللطاخات الدموية المصبوغة بصبغة جيمزا تحت المجهر، ولكن على الرغم من هذا، إلا أنَّ التمييز بين المتصورة النولسية والأنواع الأخرى من المتصورة يُمثل تحديًا؛ وذلك نظرًا لتشابهها مظهريًا.[12] تكون طفيليات المتصورة النولسية في الدَّور الحلقي عند صبغها بصبغة جميزا مشابهةً لطفيليات المتصورة المنجلية في دورها الحلقي، حيث تظهر على شكل دائرةٍ تحتوي نقطة أو نقطتين داكنتين من الكروماتين.[18] تكون الأتاريف (جمع أتروفة) القديمة أكثر تشتتًا، وتشكل شكلًا مستطيلًا منتشرًا عبر الخلية المُضيفة يُسمى "شكل النطاق"، ويشبه نفس الدور في المتصورة الوبالية الملارية.[18] تظهر النقاط خلال هذا الدور أحيانًا عبر خلايا الدم الحمراء المضيفة، وتسمى "تنقيط سينتون وموليغانز".[18] تظهر المتقسمات (جمع متقسمة) بشكلٍ مشابهٍ لأنواع المتصورة الأخرى، حيث تكون على شكل مجموعاتٍ من الأقاسيم الأرجوانية المُحاطة بصبغة مركزية داكنة اللون.[18]
يُعد التشخيص الخاطئ لعدوى المتصورة النولسية أمرًا شائعًا، حيث قد تُشخص على أنها متصورة منجلية أو وبالية ملارية أو نشيطة؛ وذلك بسبب التشابه الشكلي بين أنواع المتصورة.[16] تستطيع بعض الاختبارات التشخيصية السريعة [الإنجليزية] الكشف عن المتصورة النولسية، ولكنها تُعد ضعيفة الحساسية والنوعية، بالتالي لا يُمكن الاعتماد عليها دائمًا.[16][19] يُعتبر الكشف عن الحمض النووي بواسطة تفاعل البوليمراز المتسلسل (PCR) أو تفاعل البوليمراز المتسلسل بالزمن الحقيقي الطريقة الأكثر موثوقيةً للكشف عن المتصورة النولسية، وتمييزها عن عداوى الأنواع الأخرى للمتصورة. ولكن تفاعل البوليمراز المتسلسل يُعد اختبارًا بطيئًا ومكلفًا نسبيًا، وهو غير مُتوافر في العديد من المناطق التي يتوطن فيها المرض.[12] طُورت أيضًا طرقٌ لتضخيمٍ متساوي الحرارة بواسطة مشرع دائري (LAMP) للكشف عن المتصورة النولسية، ولكن لم تُستخدم بشكلٍ واسع حتى الآن.[12]
العلاج
تستغرق المتصورة النولسية 24 ساعة لإكمال دورتها في خلايا الدم الحمراء، ونظرًا لذلك فإنها قد تؤدي سريعًا إلى ارتفاعٍ عالٍ جدًا في مستويات الطفيليات في الدم والذي قد يؤدي لآثارٍ مُميتة.[16] بالنسبة للأشخاص المُصابين بملاريا غَيرُ مصحوبةٍ بمُضاعفات، فإنَّ منظمة الصحة العالمية تُوصي باستعمال العلاج المُركب بالأرتيميزينين (ACT) أو الكلوروكين.[20] أما في حالات الملاريا الشديدة، فإنَّ المنظمة توصي بالإعطاء الوريدي للأرتيسونات لمدةٍ لا تقل عن 24 ساعة، متبوعًا بالعلاج المُركب بالأرتيميزينين.[16] أشارت تجارب الأدوية المُبكرة أنَّ مركبات الكلوروكين والبريماكين، الأرتيسونات والمفلوكوين، والأرتيميثر واللوميفانترين، والكلوروكين لوحده قد تكون علاجات فعالة لمرض ملاريا المتصورة النولسية غير المصحوبة بمضاعفات.[16] لا يوجد دليلٌ على تطوير المتصورة النولسية لمقاومةٍ لمضادات الملاريا الحالية.[16]
الوبائيات
حسب علم الوبائيات فإنَّ المتصورة النولسية هي أكثر الأسباب شيوعًا للملاريا في ماليزيا،[2] كما وُثقت حالات ملاريا المتصورة النولسية في معظم بلدان جنوب شرق آسيا وكذلك في المسافرين من المنطقة.[12]
ترتبط عدوى المتصورة النولسية بعددٍ من العوامل الاجتماعية الاقتصادية، بالإضافة إلى عوامل نمط الحياة التي تجذب الأفراد إلى الغابات الكثيفة التي يتواجد فيها البعوض بشكلٍ شائع.[14] يُعد العاملون في الغابات أو على أطرافها مثل المزارعين والصيادين أو العاملون في قطع الأشجار معرضون بشكلٍ أكبر لخطر الإصابة بالعدوى.[14] لهذا السبب على الأرجح، يُصاب الذكور أكثر من الإناث، والبالغون أكثر من الأطفال.[14]
الأبحاث
استُخدمت المتصورة النولسية منذ فترةٍ طويلة نموذجًا بحثيًا لدراسة التفاعل بين الطفيلي والمُضيف، وتطوير اللقاحات والأدوية المضادة للملاريا.[3] تُعد النولسية مفيدةً كنموذجٍ بحثيٍ جزئيًا بسبب قدرتها على إصابة المكاك الريسوسي، الذي يُعد نموذجًا مخبريًا شائعًا من الرئيسيات. تُعد قرود المكاك الريسوسية شديدة الحساسية للإصابة بالمتصورة النولسية، وقد تُصاب بلدغة البعوض أو حقن البوغيات أو حقن طفيليات الدور الدموي.[5][3] تظهر على القردة المصابة بعض السمات المميزة للملاريا البشرية، وتتضمن فقر الدم وتضخم الطحال والكبد.[5] عادةً ما تكون العدوى قاتلة إذا لم تُعالج، وتحدث الوفاة تقريبًا بسبب فشلٍ في الدورة الدموية، والذي يتميز بالتصاق خلايا الدم الحمراء المصابة بجدران الأوعية الدموية.[5] يمكن شفاء القرود من العدوى عبر العلاج بمضادات الملاريا، كما أنَّ تكرار العدوى ثم الشفاء منها يؤدي إلى تطوير بعض القرود مناعةً للعدوى، وهو موضوعٌ بحثيٌ جوهري.[5]
تُستخدم المتصورة النولسية أيضًا في الأبحاث المخبرية ضمن علم الأحياء الخلوي للمتصورة. قد تُصيب البوغيات المعزولة خلايا الكبد الريسوسية الأولية، مما يسمح بدراسة الدور الكبدي للطفيلي في المختبر.[3] بالإضافة إلى ذلك، فإنَّ المتصورة النولسية والمنجلية هما النوعان الوحيدان من أنواع المتصورة التي يمكن الحفاظ عليها باستمرارٍ في خلايا الدم الحمراء المزروعة، في كلٍ من البشر والمكاك الريسوسي.[3] لتسهيل أبحاث علم الأحياء الجزيئي، وضُع تسلسل المجموع الوراثي للمتصورة النولسية، وهو متاحٌ على قاعدة بيانات PlasmoDB وقواعد بياناتٍ أُخرى على الإنترنت.[3] يُمكن تعديل المتصورة النولسية جينيًا في المختبر عبر نقل العدوى صناعيًا إما في نظام نموذج المكاك الريسوسي أو في زراعة خلايا الدم.[3][21] يمكن تخزين أدوار عدوى الدم والبوغيات على المدى الطويل عبر تجميدها بالجلسرولايت، مما يسمح بالحفاظ على السلالات الهامة.[4]
التاريخ

وصف الطبيب الإيطالي جوزيبي فرانكيني في عام 1927 لأول مرة ما قد يكون المتصورة النولسية، وذلك عندما لاحظ طفيليًا مميزًا عن المتصورة القُرْدوحيَّة والمتصورة النَّسْناسيَّة في دم مكاكٍ طويل الذيل.[22][23] شُوهد الطفيلي مرةً أخرى عام 1931 في مكاكٍ طويل الذيل بواسطة إتش.جي.إم كامبل أثناء عمله على الكالا آزار (داء الليشمانيات الحشوي) في كلكتا. سحب زميل كامبل ليونيل إيفرارد نابير الدم من قردٍ مُصاب ولقح ثلاثة قرودٍ مخبرية، أحدها كان مكاك ريسوسي أُصيب بعدوًى شديدة.[7][24] أعطى كامبل ونابير القرد المصاب إلى بيراج موهان داس غوبتا، حيث كان هذا القرد قادرًا على الحفاظ على الطفيل من خلال المرور المتسلسل عبر القرود.[25] في عام 1932، وصف داس غوبتا ومشرفه روبرت نولس تشكل الطفيل في دم قرد المكاك، ووضحوا أنه قد يُصيب ثلاثة مرضى من البشر (استُخدم في كل حالةٍ لإحداث الحمى على أمل علاج عدوى أخرى).[7][26] وفي عام 1932 أيضًا، وصف كل من جون سينتون وإتش.دبليو موليغان تشكل الطفيلي في خلايا الدم، وقرروا أنهُ نوعٌ مميزٌ عن الأنواع الأخرى الموصوفة، وأطلقوا عليه اسم المتصورة النولسية (الاسم العلمي: Plasmodium knowlesi) تكريمًا لروبرت نولس.[7]
بعد ذلك بوقت قصير، في عام 1935، أبلغ كل من سي. إي. فان روين وجورج آر. بايل عن استخدام عدوى المتصورة النولسية في علاج شللٍ عام في المرضى النفسيين. استمر استخدام المتصورة النولسية عاملًا حمويًا عامًّا لأمراضٍ مختلفة، وخاصةً الزهري العصبي الذي كان يُستخدم معه حتى عام 1955 على الأقل.[25] اقترح سيريل غارنهام في عام 1957 أنَّ المتصورة النولسية قد تُصيب البشر بشكلٍ طبيعي،[27] وكانت أول حالةٍ موثقةٍ لإصابة البشر بشكلٍ طبيعي بالمتصورة النولسية في عام 1965، حيث كانت في أحد الناجين من الجيش الأمريكي، والذي أُصيب بقشعريرةٍ وحمى بعد خمسة أيام من انتشار الجنود في ماليزيا.[25][28] واعتمادًا على هذه النتيجة، أجرى فريقٌ في معهد البحوث الطبية في شبه جزيرة ماليزيا دراسةً استقصائيةً للأشخاص الذين يعيشون بالقرب من قرود المكاك، ولكنهم فشلوا في العثور على دليلٍ بأنَّ ملاريا القرود تنتقل إلى البشر.[25]
خلال ستينيات وسبعينيات القرن العشرين، استَخدمت مجموعات البحث العلمي المتصورة النولسية لتكون نموذجًا بحثيًا للتوصل إلى اكتشافاتٍ أساسيةٍ في الملاريا. في عامي 1965 و1972، وصفت عدة مجموعاتٍ كيف ساهم تنوع مولدات ضد المتصورة النولسية في تفادِ المناعة والعدوى المزمنة. في عام 1975، بينَّ لويس إتش. ميلر وآخرون أنَّ المتصورة النولسية تتطلب عامل دافي على سطح خلايا الدم الحمراء لغزوها (وضحوا بعد عامٍ أنَّ المتصورة النشطية تحتاج نفس الأمر).[25]
أُعيد تنشيط العمل على المتصورة النولسية باعتبارها طفيلي الملاريا البشرية في عام 2004، وذلك عندما استخدم بالبير سينغ وآخرون تفاعل البوليميراز المتسلسل لإظهار أنَّ أكثر من نصف أفراد المجموعة من البشر والذين شخصت إصابتهم بملاريا المتصورة الوبالية في بورنيو الماليزية كانوا مصابين فعليًا بالمتصورة النولسية.[25][29] وطوال العقد التالي، استَخدم العديد من الباحثين طرق الكشف الجزيئي القادرة على تمييز المتصورة النولسية عن الطفيليات المتشابهة شكليًا لعزو نسبة متزايدة من حالات الملاريا إلى النولسية في جميع أنحاء جنوب شرق آسيا.[30] أظهر العمل على عيناتٍ أرشيفية أنَّ الإصابة بهذا الطفيلي حدثت في ماليزيا على الأقل منذ تسعينيات القرن العشرين.[31]
الهوامش
- «1»: المُتَصَوِّرَة النُّولِسِيَّة[ar 1] أو البلازموديوم النولسي أو البلَسْمُود النولسي (الاسم العلمي: Plasmodium knowlesi)، وتُعرف اختصارًا P. knowlesi.
المراجع
باللغة الإنجليزية
- Kazura JW, المحرر (2011). "Plasmodium knowlesi: Reservoir Hosts and Tracking the Emergence in Humans and Macaques". PLOS Pathog. 7 (4): e1002015. doi:10.1371/journal.ppat.1002015. PMC 3072369. PMID 21490952. الوسيط
|CitationClass=تم تجاهله (مساعدة) - "Plasmodium genomics: an approach for learning about and ending human malaria". Parasitology Research. Springer. 118 (1): 1–27. يناير 2019. doi:10.1007/s00436-018-6127-9. PMID 30402656. S2CID 53228888. الوسيط
|CitationClass=تم تجاهله (مساعدة) - "Plasmodium knowlesi: a relevant, versatile experimental malaria model". Parasitology. Cambridge University Press. 145 (1): 56–70. نوفمبر 2016. doi:10.1017/S0031182016002286. PMID 27938428. الوسيط
|CitationClass=تم تجاهله (مساعدة) - "Plasmodium knowlesi: A Malaria Parasite of Monkeys and Humans". Annual Review of Entomology (Submitted manuscript). 57: 107–121. 2012. doi:10.1146/annurev-ento-121510-133540. PMID 22149265. مؤرشف من الأصل في 23 سبتمبر 2020. الوسيط
|CitationClass=تم تجاهله (مساعدة) - "The role of Plasmodium knowlesi in the history of malaria research". Parasitology. Cambridge University Press. 145 (1): 6–17. سبتمبر 2016. doi:10.1017/S0031182016001888. PMID 27829470. الوسيط
|CitationClass=تم تجاهله (مساعدة) - Lee, Kim-Sung; Cox-Singh, Janet; Singh, Balbir (2009-04-21). "Morphological features and differential counts of Plasmodium knowles i parasites in naturally acquired human infections". Malaria Journal. 8 (1): 73. doi:10.1186/1475-2875-8-73. ISSN 1475-2875. PMC 2676309. PMID 19383118. مؤرشف من الأصل في 24 أغسطس 2019. الوسيط
|CitationClass=تم تجاهله (مساعدة)صيانة CS1: تنسيق PMC (link) - The Primate Malarias. Atlanta, GA: Division of Parasitic Diseases, U.S. Centers for Disease Control. 1971. صفحات 317–334. مؤرشف من الأصل في 7 نوفمبر 2020. اطلع عليه بتاريخ 26 أغسطس 2019. الوسيط
|CitationClass=تم تجاهله (مساعدة) - "Plasmodium Oocysts: Overlooked Targets of Mosquito Immunity". Trends in Parasitology. Elsevier. 32 (12): 979–990. December 2016. doi:10.1016/j.pt.2016.08.012. PMID 27639778. مؤرشف من الأصل في 19 يونيو 2020. الوسيط
|CitationClass=تم تجاهله (مساعدة) - Counihan, Natalie A.; Kalanon, Ming; Coppel, Ross L.; De Koning-Ward, Tania F. (2013). "Plasmodium rhoptry proteins: Why order is important". Trends in Parasitology. 29 (5): 228–36. doi:10.1016/j.pt.2013.03.003. PMID 23570755. الوسيط
|CitationClass=تم تجاهله (مساعدة) - Kemp, Louise E.; Yamamoto, Masahiro; Soldati-Favre, Dominique (2013). "Subversion of host cellular functions by the apicomplexan parasites" (PDF). FEMS Microbiology Reviews. 37 (4): 607–31. doi:10.1111/1574-6976.12013. PMID 23186105. مؤرشف من الأصل في 22 أبريل 2020. الوسيط
|CitationClass=تم تجاهله (مساعدة) - Sheiner, Lilach; Vaidya, Akhil B.; McFadden, Geoffrey I. (2013). "The metabolic roles of the endosymbiotic organelles of Toxoplasma and Plasmodium spp". Current Opinion in Microbiology. 16 (4): 452–8. doi:10.1016/j.mib.2013.07.003. PMC 3767399. PMID 23927894. الوسيط
|CitationClass=تم تجاهله (مساعدة) - "Human infections with Plasmodium knowlesi-zoonotic malaria". Clinical Microbiology and Infection. Elsevier. 21 (7): 640–648. يوليو 2015. doi:10.1016/j.cmi.2015.03.017. PMID 25843504. الوسيط
|CitationClass=تم تجاهله (مساعدة) - Garnham PC (1963). "A new sub-species of Plasmodium knowlesi in the long-tailed macaque". J Trop Med Hyg. 66: 156–8. PMID 13960457. مؤرشف من الأصل في 11 نوفمبر 2020. الوسيط
|CitationClass=تم تجاهله (مساعدة) - "Human Infections and Detection of Plasmodium knowlesi". Clinical Microbiology Reviews. 26 (2): 165–184. 2013. doi:10.1128/CMR.00079-12. PMC 3623376. PMID 23554413. الوسيط
|CitationClass=تم تجاهله (مساعدة) - "A naturally acquired quotidian-type malaria in man transferable to monkeys". Science. 149 (3686): 865. 1965. Bibcode:1965Sci...149..865C. doi:10.1126/science.149.3686.865. PMID 14332847. S2CID 27841173. الوسيط
|CitationClass=تم تجاهله (مساعدة) - "The treatment of Plasmodium knowlesi malaria". Trends in Parasitology. Elsevier. 33 (3): 242–253. مارس 2017. doi:10.1016/j.pt.2016.09.002. PMID 27707609. الوسيط
|CitationClass=تم تجاهله (مساعدة) - Hempelmann, E.; Putfarken, B.; Rangachari, K.; Wilson, R.J.M. (1986). "Immunoprecipitation of malarial acid endopeptidase". Parasitology. 92 (2): 305–312. doi:10.1017/S0031182000064076. PMID 3520446. الوسيط
|CitationClass=تم تجاهله (مساعدة) - "DPDx Malaria - Image Gallery". U.S. Centers for Disease Control and Prevention. 29 ديسمبر 2017. مؤرشف من الأصل في 1 نوفمبر 2020. اطلع عليه بتاريخ 20 يناير 2020. الوسيط
|CitationClass=تم تجاهله (مساعدة) - Parasitic Diseases (PDF) (الطبعة 7). Parasites Without Borders. صفحة 112. مؤرشف من الأصل (PDF) في 20 ديسمبر 2020. الوسيط
|CitationClass=تم تجاهله (مساعدة) - "Treatment of uncomplicated malaria caused by P. vivax, P. ovale, P. malariae, or P. knowlesi". Guidelines for the Treatment of Malaria (الطبعة 3). World Health Organization. 2015. صفحة 60. ISBN 978-92-4-154912-7. مؤرشف من الأصل في 12 نوفمبر 2020. اطلع عليه بتاريخ 22 يناير 2020. الوسيط
|CitationClass=تم تجاهله (مساعدة) - de Koning-Ward TF; Gilson PR; Crabb BS (June 2015). "Advances in molecular genetic systems in malaria". Nature Reviews Microbiology. Macmillan. 13 (6): 373–387. doi:10.1038/nrmicro3450. PMID 25978707. S2CID 19786233. الوسيط
|CitationClass=تم تجاهله (مساعدة) - Franchini G (1927) Su di un plasmodio pigmentato di una scimmia. Arch Ital Sci Med Colon 8:187–90
- "Plasmodium knowlesi: an overlooked Italian discovery?". Clinical Infectious Diseases. 53 (8): 849, author reply 849–50. أكتوبر 2011. doi:10.1093/cid/cir527. PMID 21890752. الوسيط
|CitationClass=تم تجاهله (مساعدة) - Napier LE; Campbell HGM (مايو 1932). "Observations on a Plasmodium infection which causes haemoglobinuria in certain species of monkey" (PDF). The Indian Medical Gazette: 246–249. S2CID 26553543. مؤرشف من الأصل في 28 فبراير 2019. اطلع عليه بتاريخ 27 أغسطس 2019. الوسيط
|CitationClass=تم تجاهله (مساعدة) - "Plasmodium knowlesi: The emerging zoonotic malaria parasite". Acta Tropica. 125 (2): 191–201. 2013. doi:10.1016/j.actatropica.2012.10.008. PMID 23088834. الوسيط
|CitationClass=تم تجاهله (مساعدة) - "A study of monkey malaria, and its experimental transmission to man". Indian Medical Gazette. 67 (6): 301–320. يونيو 1932. PMC 5231565. PMID 29010910. الوسيط
|CitationClass=تم تجاهله (مساعدة) - "The tissue stages and sporogony of Plasmodium knowlesi". Trans R Soc Trop Med Hyg. 51 (5): 384–396. 1957. doi:10.1016/0035-9203(57)90071-8. PMID 13467997. الوسيط
|CitationClass=تم تجاهله (مساعدة) - Mason Dentinger, R (26 أغسطس 2015). "Patterns of Infection and Patterns of Evolution: How a Malaria Parasite Brought "Monkeys and Man" Closer Together in the 1960s". Journal of the History of Biology. 49 (2): 359–395. doi:10.1007/s10739-015-9421-8. PMID 26307748. الوسيط
|CitationClass=تم تجاهله (مساعدة) - "A large focus of naturally acquired Plasmodium knowlesi infections in human beings" (PDF). Lancet. 363 (9414): 1017–24. 2004. doi:10.1016/S0140-6736(04)15836-4. PMID 15051281. S2CID 7776536. مؤرشف من الأصل (PDF) في 23 يوليو 2018. الوسيط
|CitationClass=تم تجاهله (مساعدة) - "Plasmodium knowlesi in humans, macaques and mosquitoes in peninsular Malaysia". Parasit Vectors. 1 (1): 26. 2008. doi:10.1186/1756-3305-1-26. PMC 2531168. PMID 18710577. الوسيط
|CitationClass=تم تجاهله (مساعدة) - Lee KS; Cox-Singh J; Brooke G; Matusop A; Singh B (2009). "Plasmodium knowlesi from archival blood films: Further evidence that human infections are widely distributed and not newly emergent in Malaysian Borneo". Int J Parasitol. 39 (10): 1125–1128. doi:10.1016/j.ijpara.2009.03.003. PMC 2722692. PMID 19358848. الوسيط
|CitationClass=تم تجاهله (مساعدة)
باللغة العربيَّة
- حسب:
- الخياط، محمد هيثم (2006). المعجم الطبي الموحد (الطبعة الرابعة). منظمة الصحة العالمية. صفحة 1605. ISBN 9953337268. اطلع عليه بتاريخ 22 نوفمبر 2020م. الوسيط
|CitationClass=تم تجاهله (مساعدة); تحقق من التاريخ في:|تاريخ الوصول=(مساعدة) - معجم الصيدلة الموحد (PDF) (الطبعة الثانية). منظمة الصحة العالمية. 2007. صفحة 257. ISBN 9953334692. اطلع عليه بتاريخ 22 نوفمبر 2020م. الوسيط
|CitationClass=تم تجاهله (مساعدة); تحقق من التاريخ في:|تاريخ الوصول=(مساعدة) - جون، ديفيد; بيتري، ويليام (2012). ماركيل وفوغ الطفيليات الطبية: الطبعة العربية. تُرجم بواسطة بارة، فرج; بارة، منى (الطبعة الأولى). إلزيفير. صفحة 96A. ISBN 9780702054723. مؤرشف من الأصل في 22 نوفمبر 2020م. اطلع عليه بتاريخ 22 نوفمبر 2020م. الوسيط
|CitationClass=تم تجاهله (مساعدة); تحقق من التاريخ في:|تاريخ الوصول=, |تاريخ أرشيف=(مساعدة)
- الخياط، محمد هيثم (2006). المعجم الطبي الموحد (الطبعة الرابعة). منظمة الصحة العالمية. صفحة 1605. ISBN 9953337268. اطلع عليه بتاريخ 22 نوفمبر 2020م. الوسيط
روابط خارجية
صور وملفات صوتية من كومنز
أنواع من ويكي أنواع.
- صفحة الملاريا على موقع مراكز السيطرة على الأمراض والوقاية منها (بالإنجليزية)
- صفحة الملاريا على موقع منظمة الصحة العالمية (بالإنجليزية)
- فيلمٌ قصير حول اكتشاف دور المتصورة النولسية في الملاريا البشرية (بالإنجليزية)
- بيانات جنيوم (المجموع المورثي) للمتصورة النولسية
- بوابة طب
- بوابة علم الأحياء
- بوابة علم الأحياء الدقيقة
